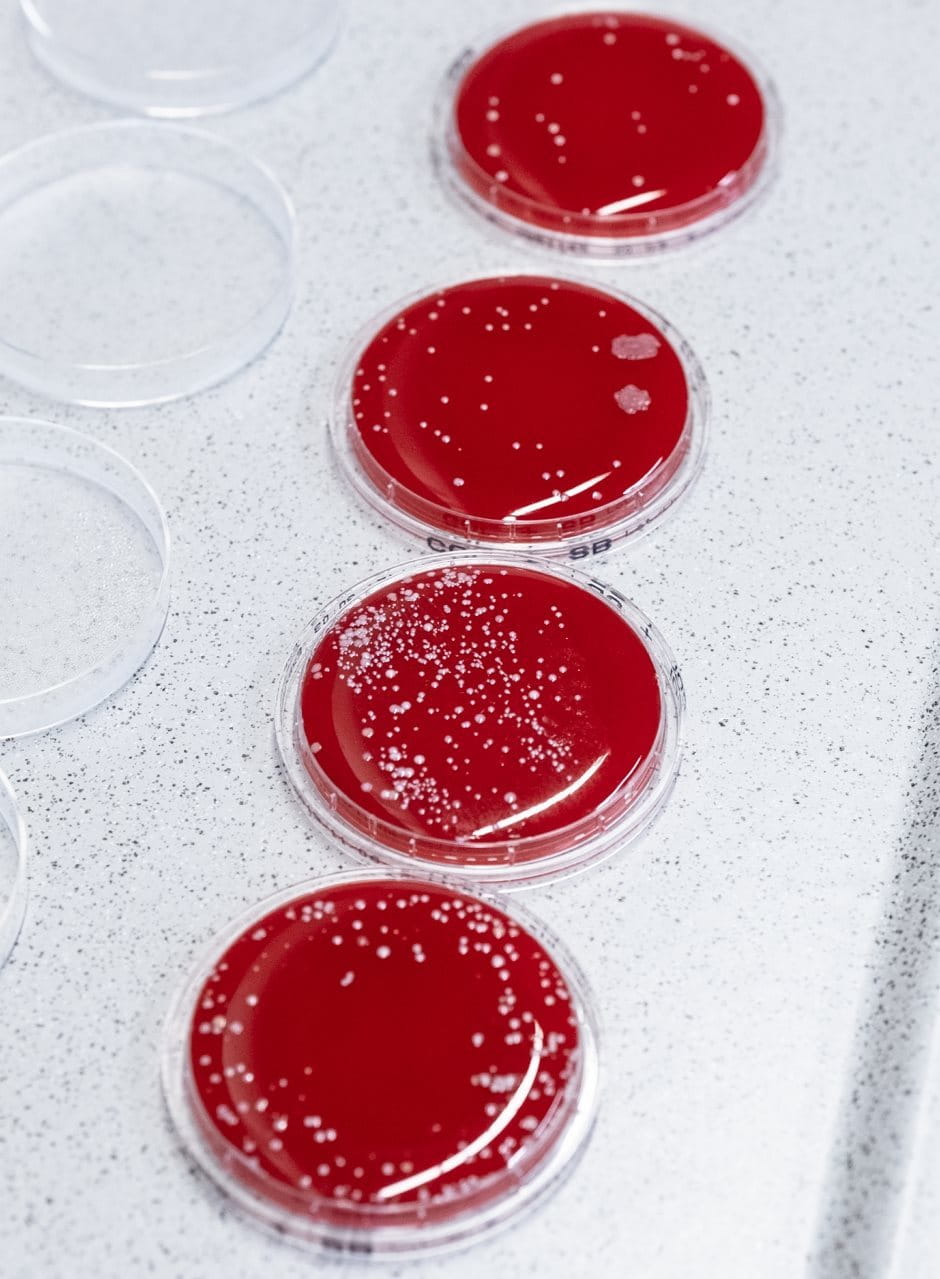

Beiersdorf has been successfully exploring
microbiological topics for around twenty-five years. As a main focus, the skin
microbiome increasingly moved into the spotlight in 2018 – with unmistakable
results in the market: the “Microbiome Balance” rating distinguishes
the special product portfolio as particularly gentle on the skin. “However, we don’t have to imagine that the global research community has
truly understood the skin microbiome yet,” says Dr. Jennifer Hüpeden with
a twinkle in her eye. But thanks to ongoing research, light is increasingly
being shed on the subject. The recent cooperation with Professors Holger
Brüggemann from Aarhus University and Wolfgang Streit from the University of
Hamburg is an example of this, which also stands for the promotion of young
scientists.
“If it fits thematically, we are happy to open
our doors to students on a regular basis,” explains Dr. Hendrik Reuter,
Head of Microbiome Research at Beiersdorf. For Charlotte Ahle, a student in the
biology department at the University of Hamburg, the opportunity presented
itself. The doctoral student not only took a close look at the skin’s microbial
zoo. In order to be able to identify the staphylococcus group of bacteria more
precisely, she developed a new molecular biological method as a first step,
which Beiersdorf has patented and is using successfully.
For Charlotte Ahle,
the results are also personally impressive: After three years of intensive
research, she is pleased to have been awarded her doctorate and at the same
time can be proud of three scientific publications in prestigious journals. Dr.
Hendrik Reuter comments: “For scientists, the publication of their studies
is very important, because the work is judged by other researchers and
accessible to the professional world. The three journals in which Charlotte’s
study results have appeared, have gotten a high reputation and are a great
example of successful cooperation between science and industry.”